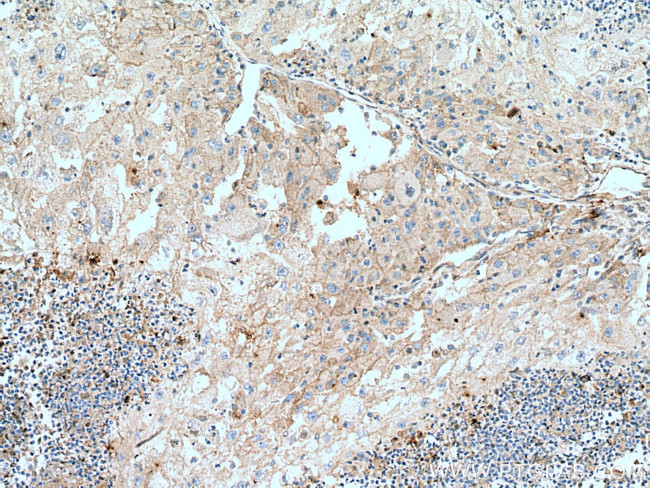
Transferrin Antibody in Immunohistochemistry (Paraffin) (IHC (P))

Search
Proteintech
Transferrin Monoclonal Antibody (2B4C6)
{{$productOrderCtrl.translations['antibody.pdp.commerceCard.promotion.promotions']}}
{{$productOrderCtrl.translations['antibody.pdp.commerceCard.promotion.viewpromo']}}
{{$productOrderCtrl.translations['antibody.pdp.commerceCard.promotion.promocode']}}: {{promo.promoCode}} {{promo.promoTitle}} {{promo.promoDescription}}. {{$productOrderCtrl.translations['antibody.pdp.commerceCard.promotion.learnmore']}}
产品信息
66171-1-IG
种属反应
已发表种属
宿主/亚型
分类
类型
克隆号
抗原
偶联物
形式
浓度
规格
纯化类型
保存液
内含物
保存条件
运输条件
产品详细信息
Immunogen sequence: EGTCQEAPT DECKPVKWCA LSHHERLKCD EWSVNSVGKI ECVSAETTED CIAKIMNGEA DAMSLDGGFV YIAGKCGLVP VLAENYNKSD NCEDTPEAGY FAVAVVKKSA SDLTWDNLKG KKSCHTAVGR TAGWNIPMGL LYNKINHCRF DEFFSEGCAP GSKKDSSLCK LCMGSGLNLC EPNNKEGYYG YTGAFRCLVE KGDVAFVKHQ TVPQNTGGKN PDPWAKNLNE KDYELLCLDG TRKPVEEYAN CHLARAPNHA VVTRKDKEAC VHKILRQQQH LFGSNVTDCS GNFCLFRSET KDLLFRDDTV CLAKLHDRNT YEKYLGEEYV KAVGNLRKCS TSSLLEACTF RRP (347-698 aa encoded by BC059367)
靶标信息
Transferrins (Tf) are an approximately 80kDa blood plasma glycoprotein synthesized by the liver. They are iron binding transport proteins which can bind two Fe(3+) ions in association with the binding of an anion, usually bicarbonate. It is responsible for the transport of iron from sites of absorption and heme degradation to those of storage and utilization. Transferrin is the primary blood iron transport protein and under normal conditions; approximately one-third of total blood transferrin contains bound iron. Measurement of blood transferrin levels can be used as an indicator for blood iron-carrying capacity and abnormalities of iron metabolism such as anaemia, iron overload and haemochromatosis.Serum transferrin may also have a further role in stimulating cell proliferation.
仅用于科研。不用于诊断过程。未经明确授权不得转售。
生物信息学
蛋白别名: Beta-1 metal-binding globulin; DKFZp781D0156; epididymis secretory sperm binding protein Li 71p; Serotransferrin; Siderophilin; transferin; Transferrin; transferrin precursor; unnamed protein product
基因别名: HEL-S-71p; PRO1400; PRO1557; PRO2086; TF; TFQTL1
UniProt ID: (Human) P02787
Entrez Gene ID: (Human) 7018